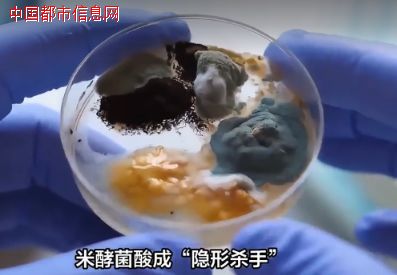

中国都市信息网讯:记者朱杰近期,广东报告2起米酵菌酸毒素引起的食物中毒事件。造成2人死亡。平均病死率42%!中毒无特效药!米酵菌酸中毒事件确实令人揪心,米酵菌酸毒素1毫克即可致命且无特效药,这需要特别警惕。
米酵菌酸中毒事件并非个案:
2023年7月,河南永城两人疑似吃凉皮后中毒致1死1伤的新闻引发关注。医生向家属称,两人是米酵菌酸中毒。
2021年7月,广东汕头市报告1起米酵菌酸食物中毒事件,发病4例、死亡1例。
2019年7月26日晚,家住杭州闲林的张先生(化名)被家属扶进杭州市西溪医院急诊抢救室。检查结果显示张先生肝、肾功能衰竭,严重凝血功能障碍。家属说,张先生平时身体不错,前一天晚上吃了青菜和隔夜泡发的凉拌黑木耳,医生认为张先生是吃了隔夜泡发的黑木耳而导致“米酵酸菌”中毒。
图:紧急提醒:米酵菌酸毒素死亡2例 无特效药
米酵菌酸,一种由唐菖蒲伯克霍尔德氏菌在繁殖过程中产生的剧毒毒素。唐菖蒲伯克霍尔德氏菌在自然环境中分布广泛,适宜生长温度范围较广,最适生长温度36摄氏度至37摄氏度,最适产毒温度26摄氏度至28摄氏度。
需要长时间发酵或浸泡的食物最受米酵菌酸偏爱,如发酵玉米面(酸汤子)、发酵糯玉米汤圆粉等谷类发酵制品,河粉、粿条、米线等高水分谷薯类制品,以及泡发不当的银耳、木耳。以上食品的原料易受到唐菖蒲伯克霍尔德氏菌的污染,当制作加工过程中卫生条件差、生熟交叉污染或者是储存不当,更易导致该菌大量繁殖并产毒。
2003~2017年全国食源性疾病暴发监测数据显示,米酵菌酸是我国迄今为止导致食源性疾病暴发病死率最高的致病因子,平均病死率高达42%。
专家介绍,由于中毒早期消化道症状不甚明显,很多患者出现早期症状都没有引起重视,误以为一般的胃肠炎或者是胃肠不适,未及时就医以致错过最佳治疗时机。
不仅发病隐匿,米酵菌酸中毒患者病情发展迅速,目前尚未有特效解毒药物,毒素进入人体后会迅速分布到肝、脑、肾等重要器官,造成持续性损害。“重症中毒患者治疗相当困难,中毒发生后病情持续进展,最终出现多器官功能衰竭导致死亡。”
米酵菌酸中毒有哪些症状?
患者主要表现为呕吐、腹泻、全身无力等症状,严重者可出现黄疸、皮下出血、昏迷、谵语、少尿、血尿等肝、脑、肾的损害症状,重症患者出现血压下降、潮式呼吸,最后呼吸麻痹而死亡。一般无发热。
米酵菌酸中毒潜伏期一般30分钟到24小时,少部分可延长至1至2天或更长。
当中毒发生时,应立即停止进食可疑食物;第一时间催吐,减少毒素吸收;尽量保存可疑的致病食物,并及时就医。
提醒:这些食物容易产生米酵菌酸
米酵菌酸中毒是我国病死率较高的一种微生物性食源性疾病。中毒食品主要为家庭自制发酵食品,常见的有三类:
一是发酵玉米面制品,如酸汤子、臭碴子、糯玉米汤圆、吊浆粑等。
二是变质鲜银耳。
三是发酵薯类制品,如马铃薯粉条、甘薯面、山芋淀粉等。
近年来,我国部分地区相继发生由鲜湿粉(如河粉)、凉皮及泡发木耳引起的中毒事件。
做到这三点避免中毒
米酵菌酸无色、味,可耐120℃高温,在酸性条件、氧化剂和日光下均稳定,被其污染的食物可有正常的外观和味道,一般的烹调方法不能完全破坏其毒性。
日常生活中如何避免米酵菌酸中毒?专家给出三个要点:
一是正规渠道购买并妥善保存,凡超过保质期均应舍弃。尤其是河粉、肠粉、陈村粉、粿条、米线等湿米粉。
二是食用木耳、银耳等菌类前应检查其感官性状,变质的不能食用;泡发菌类时间不宜过长、不宜隔夜,泡发后应及时加工食用;不采食鲜银耳或鲜木耳,尤其是已变质的鲜银耳或鲜木耳。
三是家庭自制谷类发酵食品,应避免使用霉变的玉米等原料,谷类浸泡时需勤换水,制作及贮藏过程中需注意保持卫生与通风防潮,避免污染。
来源:中国新闻社、广东省卫生健康委官网、健康中国、中国都市信息网等媒体平台!





